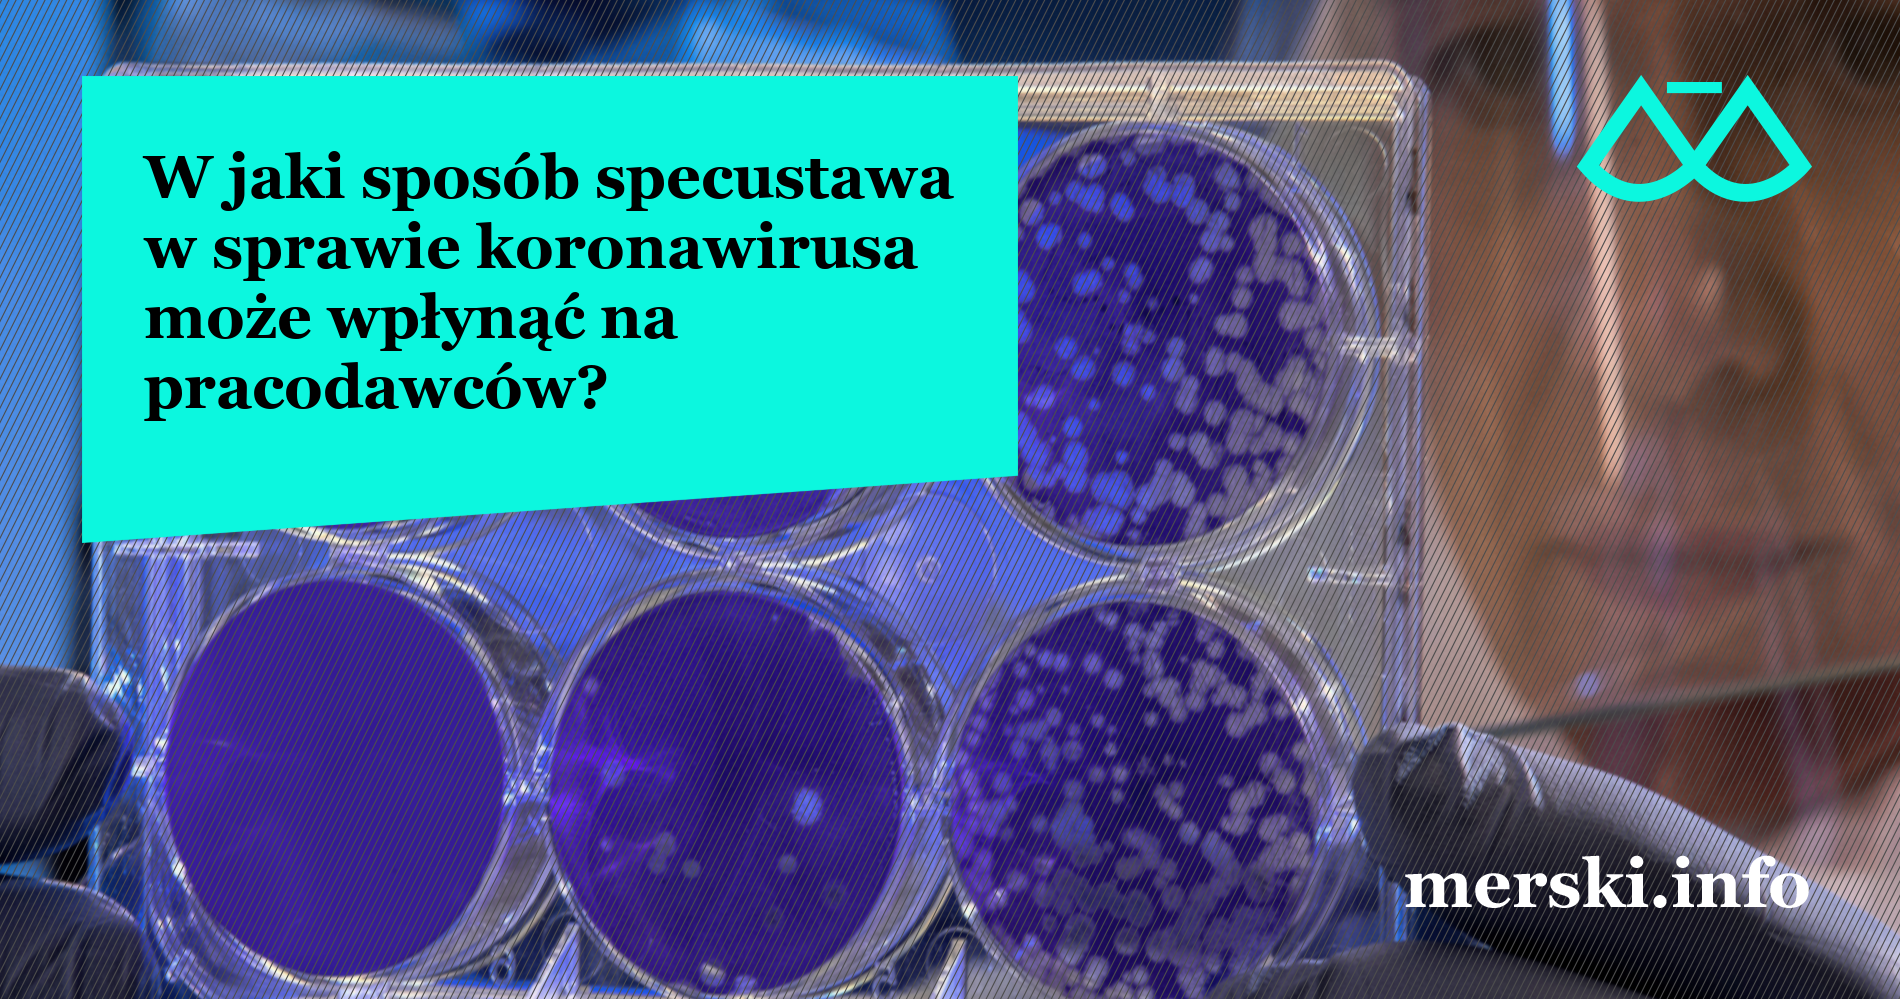

W poprzednim artykule (link) opisaliśmy ogólne zasady wynikające z kodeksu pracy dotyczące zakazu dyskryminacji pracowników zdalnych. Zgodnie z przepisami pracownik nie może być w jakikolwiek sposób dyskryminowany z powodu wykonywania pracy zdalnej, jak również z powodu odmowy wykonywania takiej pracy. Obecnie jednak problemem, z którym mierzą się pracodawcy nie jest brak zgody pracownika na wykonywanie... Czytaj dalej →
Owocowe czwartki tylko w biurze? O dyskryminacji pracowników zdalnych
Kodeks pracy zabrania jakiejkolwiek dyskryminacji w zatrudnieniu, bezpośredniej lub pośredniej, w szczególności ze względu na płeć, wiek, niepełnosprawność, rasę, religię, narodowość, przekonania polityczne, przynależność związkową, pochodzenie etniczne, wyznanie, orientację seksualną, zatrudnienie na czas określony lub nieokreślony, zatrudnienie w pełnym lub w niepełnym wymiarze czasu pracy (art. 113 k.p.). Pomimo że katalog przesłanek dyskryminacyjnych wskazanych w... Czytaj dalej →
Czy dopuszczalne jest łączenie różnych systemów czasu pracy w ramach jednego stosunku pracy, na jednym stanowisku?
Coraz częściej, w kontekście pracy zdalnej i hybrydowej, pojawia się pytanie o możliwość stosowania różnych systemów czasu pracy (np. podstawowego i zadaniowego) dla jednego pracownika, w zależności od miejsca wykonywania obowiązków – z biura lub z domu. Czy można zatem stosować dwa różne systemy czasu pracy wobec jednego pracownika – np. podstawowy system czasu pracy... Czytaj dalej →
Kontrole trzeźwości i praca zdalna na ostatniej prostej.
Wygląda na to, że powoli dobiegają do końca parlamentarne prace nad oczekiwaną nowelizacją Kodeksu pracy regulującą zasady prowadzenia kontroli trzeźwości i wykonywania pracy zdalnej. Wszystko jednak wskazuje na to, że na ich wejście w życie trzeba będzie poczekać do przyszłego roku. Poprawki Senatu Po uchwaleniu ustawy przez Sejm, Senat wprowadził do niej kilka poprawek, w... Czytaj dalej →
Projekt przepisów o pracy zdalnej i kontrolach trzeźwości trafił do Sejmu
Po niemal roku prac w ramach rządowego procesu legislacyjnego projekt został w końcu przekazany do parlamentu. Poniżej przedstawiamy kilka najważniejszych informacji o założeniach dotyczących pracy zdalnej. Praca zdalna nie tylko w czasie epidemii Przypomnijmy, że projekt zakłada wprowadzenie pracy zdalnej jako stałego rozwiązania, niepowiązanego w żaden sposób z aktualną sytuacją epidemiczną. Tym samym, wraz z... Czytaj dalej →
Długo wyczekiwany projekt przepisów o pracy zdalnej
W ostatnich dniach pojawiły się dwa, długo oczekiwane projekty ustaw zmieniających przepisy Kodeksu pracy. Jeden z nich dotyczy pracy zdalnej i kontroli trzeźwości, drugi dotyczy m.in. obowiązków informacyjnych pracodawcy, umów terminowych oraz uprawnień rodzicielskich. Poniżej przedstawiamy krótkie omówienie projektowanych przepisów w zakresie pracy zdalnej ze szczególnym uwzględnieniem zasad ponoszenia przez pracodawców kosztów wykonywania pracy zdalnej. ... Czytaj dalej →
W jaki sposób specustawa w sprawie koronawirusa może wpłynąć na pracodawców?
Przyjęta w poniedziałek 2 marca ustawa związana z przeciwdziałaniem rozpowszechnianiu się wirusa SARS-CoV-2 i wywoływanej przez niego choroby COVID-19 oddziaływać może też na pracodawców. Jakie najważniejsze rozwiązania zostały w niej zapisane? Praca zdalna na polecenie pracodawcy Przede wszystkim, w celu przeciwdziałania COVID-19 pracodawca będzie mógł polecić pracownikowi wykonywanie, przez czas oznaczony, pracy określonej w umowie... Czytaj dalej →